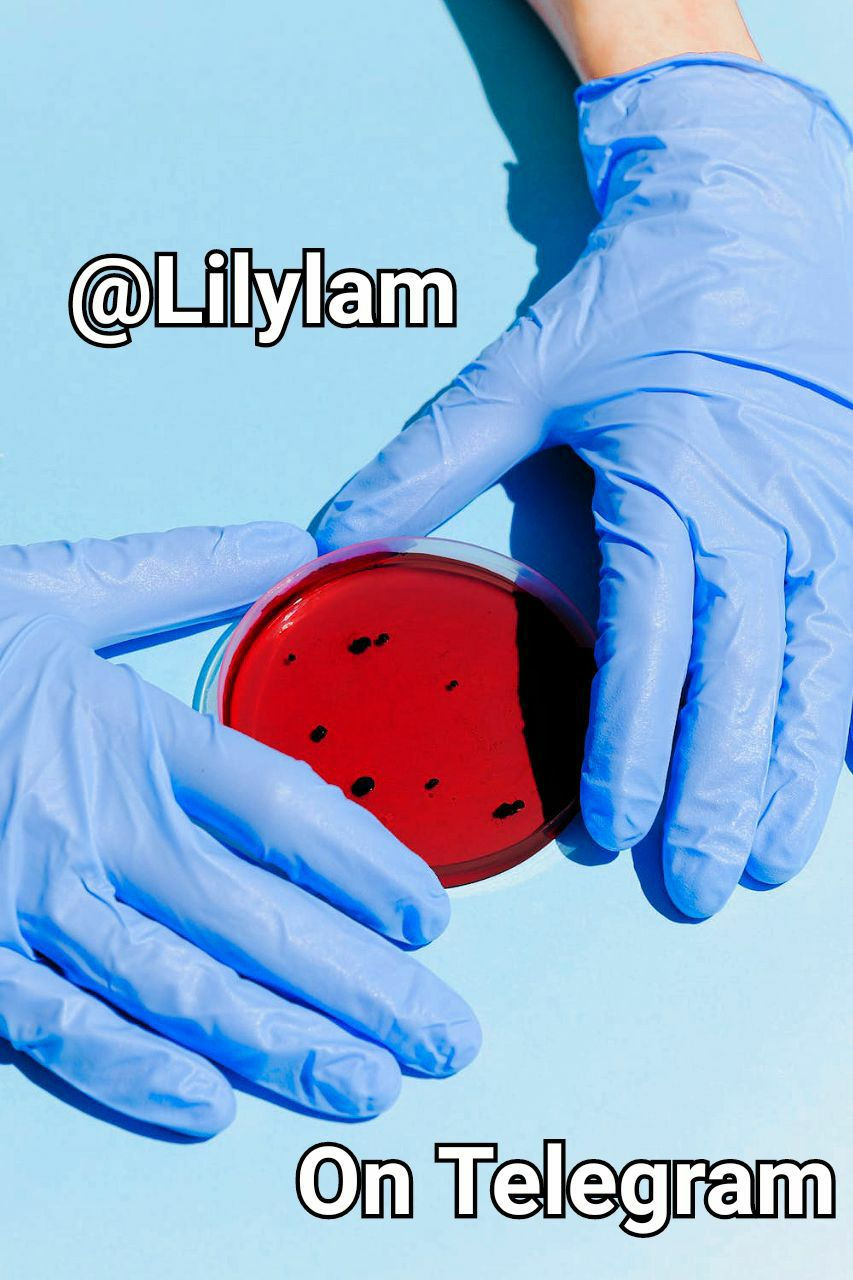
Blood 💉🩸🩸🩸🩸🩸

Physics Notes
- Just Neet
- Apr 26, 2020
- 1 min read
🍎 Handwritten Notes
🏆Sepratedeprated Volumes Physics
🌀Class 11th👇
https://drive.google.com/drive/mobile/folders/167pXwdn8Lq86Z37-vfPm_X2Cg7gsPpfW/16CFxvw0VGU2tBglUJB5WpKh09_gFjNpS?sort=13&direction=a
🌀Class 12th👇
https://drive.google.com/drive/mobile/folders/167pXwdn8Lq86Z37-vfPm_X2Cg7gsPpfW/16H-FW6X_7pgmCkV56Z-EiMPwVZ7BHYy9?sort=13&direction=
Join For More @Girlrules
Share & Support
https://t.me/Neet711
Sorry Kal 9 Am ko Ready rahana Quiz k liye
🍁FOR MORE JOIN GIRLS-DOMINANT👇🏻@Girlrules❤️ @Neet711 Here
🌸🌺 FOLLOW US ON YouTube FOR MORE CHARTS AND MNEMONIC - https://www.youtube.com/joykart

Comments